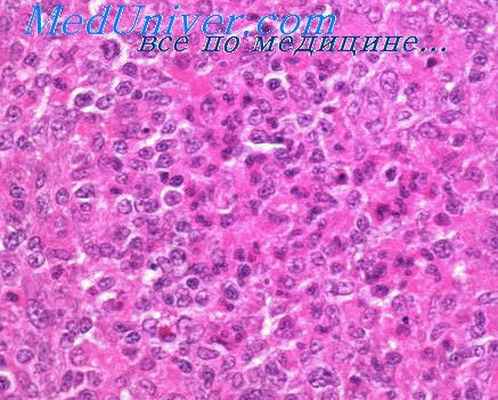
хламидии

Респираторный хламидиоз. Риккетсиозы
Добавил пользователь Валентин П. Обновлено: 14.12.2025
Самыми частыми осложнениями ОРЗ являются бактериальные суперинфекции. Развиваются они обычно на пятый–седьмой день и чаще сопровождаются ухудшением симптомов. Наиболее распространённые осложнения — синусит, тонзиллит, фарингит, бронхит и пневмония. Рассказываем, что такое азитромицин и как он поможет при инфекциях дыхательных путей.
Антибиотик азитромицин используют при инфекциях дыхательных путей из-за двух его основных особенностей (обращаем внимание, что перед приёмом лекарства необходимо проконсультироваться со специалистом). Первая — это способность препарата создавать высокие концентрации в лёгочной ткани, слизистой бронхов, бронхиальном секрете и жидкости, покрывающей альвеолярный эпителий, которые сохраняются в течение длительного времени.
Второй особенностью препарата является высокая активность лекарства в отношении не только классических патогенных микроорганизмов, но и атипичных, таких как Mycoplasma pneumoniae (вызывает микоплазменную пневмонию, — прим. Ф.) , Chlamydia spp. (вызывает хламидиоз,— прим. Ф.) и Legionella spp. (вызывает легионеллёз — острое инфекционное заболевание, заболевание протекает с выраженной лихорадкой, общей интоксикацией, поражением лёгких, центральной нервной системы, а также системы пищеварения, — прим. Ф).

Фото предоставлено рекламодателем
О препарате
Азитромицин — полусинтетический азалидный антибиотик из группы макролидов (группа антибиотиков основу химической структуры которых составляет макроциклическое лактонное кольцо с одним или несколькими углеводными остатками, — прим. Ф.). Препарат подавляет рост и размножение бактерий. Он эффективен в отношении не только внеклеточных, но и внутриклеточных возбудителей.
Действие препарата во много раз сильнее эритромицина — первого макролида, который до этого широко применяли в медицине. Среди всех макролидов азитромицин сильнее всего воздействует на гонококки (возбудители гонореи, — прим. Ф.), моракселла катаралис (может вызывать инфекции не только дыхательной системы, но и среднего уха, глаза, центральной нервной системы и суставов человека, прилипая к клетке-хозяину, — прим. Ф.), гемофильную палочку, бруцеллы (вызывают бруцеллез — поражение различных систем организма: опорно-двигательного аппарата, нервной и других, — прим. Ф.), риккетсии (вызывают разные болезни, например риккетсиозы, которые влекут за собой тиф или другие лихорадки, — прим. Ф.). Кроме этого, азитромицин также обладает постантибиотическими и противовоспалительными эффектами.
Где применяется препарат?
Азитромицин в большинстве случаев является антибиотиком выбора при респираторных заболеваниях, но также применяется при лечении многих других болезней. В частности, препарат назначают при внебольничной пневмонии, обострениях хронической обструктивной болезни лёгких бактериального характера. Как правило, для лечения и профилактики.
Также его назначают при тонзиллите, фарингите, среднем отите, остром бактериальном синусите, ородентальных инфекциях, инфекциях кожи и мягких тканей, инфекциях, передающихся половым путём, кишечных инфекциях и других. Азитромицин включают в схему комбинированной терапии язвенной болезни для уничтожения бактерии Helicobacter pylori (бактерия, которая инфицирует различные области желудка и двенадцатиперстной кишки, — прим. Ф).

Фото предоставлено рекламодателем
Насколько безопасен азитромицин?
Азитромицин, по мнению специалистов, считается эффективнее многих других антибиотиков, которые используют при лечении инфекционных болезней респираторного тракта. При этом для достижения необходимого терапевтического действия требуется менее продолжительный курс терапии, чем при использовании других антибиотиков или даже других групп лекарств. Азитромицин — один из наименее токсичных антибиотиков, поэтому и частота развития побочных эффектов при лечении этим препаратом гораздо ниже. Он одинаково безопасен для взрослых и детей. Исследования на беременных женщинах не проводились, но в экспериментах на животных эмбриотоксическое действие не выявили.
Где купить препарат?
uchebnik
Риккетсии - это бактерии, отличительной биологической особенностью которых является облигатный внутриклеточный паразитизм. Риккетсии выделены в отдельный порядок Rickettsiales.
Клетки риккетсий полиморфные (палочковидные, кокковидные, нитевидные), грамотрицательные. Спор, капсул не образуют, неподвижны.
У риккетсий имеются различные ферменты и им присущи многие обменные процессы. Однако в процессе эволюции они утратили некоторые энзимные системы, необходимые для синтеза отдельных жизненно важных биополимеров, и поэтому перешли к паразитическому образу жизни.
Патогенные для человека риккетсии не способны размножаться на бесклеточных средах (исключение R.quintana). Для их культивирования применяют те же методы, что и для культивирования вирусов: заражение культуры тканей, культивирование в развивающихся куриных эмбрионах, организме экспериментальных животных или эктопаразитов.
Риккетсии имеют два антигена - растворимый (группоспецифический) и корпускулярный (видоспецифический).
Риккетсии образуют отдельный порядок Rickettsiales. Патогенными для человека являются представители одного из 3 семейств - Rickettsiaceae, которое делится на трибы: Rickettsieae, Erlichieae и Wolbachieae. Основную роль в патологии человека играют риккетсии трибы Rickettsieae, состоящей из 3 родов: Rickettsieae, Rochalimaea и Cоxiella, а также представители трибы Ehrlichieae.
Деление риккетсий на рода основано на различии в антигенном строении и локализации риккетсий в пораженной клетке. Возбудители относящиеся к роду Rickettisia располагаются в цитоплазме, реже в ядре клеток хозяина, роду Coxiella - в фагосомах и фаголизосомах, а роду Rochalimaea - в межклеточных пространствах.
Патогенные риккетсии образуют токсические вещества (природа которых окончательно не установлена). Они нестойки, легко разрушаются, обладают гемолитической активностью и вызывают парез кровеносных сосудов.
Заболевания, вызываемые риккесиями, носят общее название риккетсиозов. Два из них - эпидемический сыпной тиф (возбудитель R. prowazekii) и волынская лихорадка (возбудитель R. quintana) являются антропонозными инфекциями. Для большинства других риккетсий основным резервуаром являются грызуны и членистоногие. Риккетсиозы – трансмиссивные инфекции. Возбудитель передается человеку при укусе кровососущих членистоногих (вши, блохи, клещи). Лишь Ку-лихорадка
(возбудитель C.burneti) передается алиментарным или воздушно-капельным путем, а естественным хозяином ее возбудителя является домашний скот.
Большинство риккетсиозов относится к природно-очаговым инфекциям. Об этом свидетельствуют и их названия - марсельская, волынская лихорадка, североазиатский риккетсиоз и др. Лишь сыпной тиф, один из наиболее тяжелых риккетсиозов, распространен повсеместно.
Риккетсии поражают клетки ретикулоэндотелиальной системы и эндотелия сосудов. В основе патогенеза риккетсиозов лежит интоксикация и развитие характерных изменений в эндотелии артериол и капилляров в виде эндоваскулита. Как следствие возникают тромбозы, стазы и кровоизлияния в различных органах и тканях, в том числе ЦНС.
Для клинике всех риккетсиозов характерными симптомами является выраженная интоксикация и геморрагии. Смерть наступает в результате развития острой сердечной недостаточности и поражения ЦНС.
Постинфекционный иммунитет - длительный, стойкий.
Основным методом микробиологической диагностики риккетсиозов является серологическое исследование (РА, РПГА, РСК с соответствующими риккетсиозными диагностикумами). Выделение риккетсий возможно только в специальных лабораториях строгого режима.
Для этиотропной терапии используют антибиотики группы тетрациклина и хлорамфеникол (левомицетин). Менее эффективны антибиотики - макролиды.
Специфическая профилактика разработана в отношении двух риккетсиозов: сыпного тифа и Ку-лихорадки. Она проводится по эпидпоказаниям живой или химической сыпнотифозной вакциной и живой вакциной из риккетсий Бернета.
Глава 19. Хламидии.
Хламидии относятся к семейству Chlamydiaceae, роду Chlamydia. Хламидии - прокариоты, отличительной биологической особенностью
которых является облигатный внутриклеточный паразитизм. Это “энергетические паразиты” клеток. Для них характерен уникальный цикл развития, включающий две различные по морфологическим и биологическим свойствам формы существования. Это элементарные и инициальные (ретикулярные) тельца.
Хламидии - кокковидные бактерии (0,3-1,5 мкм), неподвижны, капсул не образуют. Грамотрицательны.
Цикл развития хламидий протекает в цитоплазматических включениях. Проникшие в клетку элементарные тельца (инфекционная форма) превращаются в ретикулярные тельца (вегетативная форма). Они размножаются путем бинарного деления и превращаются в элементарные тельца нового поколения. Такой цикл продолжается 40-72 часа и обычно завершается разрывом клетки и выходом элементарных телец хламидий в межклеточное пространство. Помимо такого репродуктивного цикла в неблагоприятных условиях реализуются и
другие механизмы взаимодействия хламидий
с клеткой хозяина. Это
деструкция хламидий в фагосомах, L-подобная трансформация и персистенция.
Трансформированные и персистентные
формы хламидий способны
реверсировать в исходные (ретикулярные) формы с последующим преобразованием в элементарные тельца, т.е. в инфекционные частицы.
Респираторный хламидиоз. Риккетсиозы
Респираторный хламидиоз. Риккетсиозы
Респираторный хламидиоз — антропонозная инфекция, характеризующаяся поражением верхних дыхательных путей и легких.
Возбудитель — представитель недавно описанного вида С. pneumoniae
Источник инфекции — больной человек, главный путь передачи — воздушно-капельный. Восприимчивость людей высокая. Максимум заболеваемости падает на холодное время года. Болеют лица всех возрастов.
Клинически и эпидемиологически респираторный хламидиоз неотличим от ОРЗ, пневмоний другой этиологии. Тяжелые формы по клинической симптоматике напоминают орнитоз. Положительная РСК с орнитозным антигеном позволяет заподозрить хламидийную природу заболевания. Верификация диагноза возможна при наличии моноклональных антител к С. pneumoniae.
Лечение и профилактика как при других антропонозных хламидиозах. Специфическая профилактика не разработана.
Риккетсиозы
Патогенные для человека риккетсий относятся к порядку Rickettsiales, семейству Rickettsiaceae, трибу Rickettsieae, включающему род Rickettsia da Rocha-Lima, 1916 и род Coxiella Philip, 1948. После 1993 г. из порядка Rickettsiales исключен род Bartonella (ранее Rochalimaea Macchiavello, 1947) семейства Bartonellaceae в связи со способностью бартонелл к внеклеточному паразитированию.
С бактериями их сближает клеточное строение, наличие двух нуклеиновых кислот — ДНК и РНК, многослойной клеточной оболочки, цитоплазмы, зернистых включений, чувствительность к антибиотикам и наличие фага к некоторым видам риккетсий, с вирусами — паразитирование в цитоплазме и ядрах (риккетсий группы клещевой пятнистой лихорадки) мезоэндотелиальных клеток.
У риккетсий обнаружены токсины, гемолизин, обладающие антигенными свойствами
Ведущий механизм заражения риккетсиозами — трансмиссивный, за исключением тифа блошиного эндемического, заражение которым происходит в основном алиментарным путем, и Ку-лихорадки, возбудитель которой попадает в организм человека преимущественно с помощью аэрозольного механизма передачи (последний может иметь место в лабораторных условиях и при других риккетсиозах) Важное значение имеет возможность распространения некоторых риккетсий (Coxiella burnetii, Orientia tsutsugamushi) при гемотрансфузиях.
В зависимости от источника возбудителей риккетсиозы подразделяются на две эпидемиологические группы антропонозы, при которых возбудитель циркулирует между человеком и его специфическими эктопаразитами — вшами (тиф сыпной эпидемический, траншейная, или высокая лихорадка), и зоонозы, возбудители которых циркулируют между животными и их эктопаразитами Зоонозные риккетсиозы — природно-очаговые инфекции, приуроченные к определенным географическим ландшафтам, где имеется достаточная по численности популяция чувствительных животных (млекопитающих, птиц) и кровососущих членистоногих.
Из последних основное значение в распространении риккетсий имеют иксодовые клещи, которые ввиду трансовариальной и трансфазовой передачи возбудителей становятся длительными и стойкими резервуарами инфекции в природных очагах.
Информация на сайте подлежит консультации лечащим врачом и не заменяет очной консультации с ним.
См. подробнее в пользовательском соглашении.
Патогенные риккетсии и хламидии
Риккетсии:
кокковидные – до 0,1 мкм;
палочковидные – до 1-1,5 мкм
бациллярные – до 3-4 мкм;
нитевидные формы – до 10 (40)
мкм.
Вегетативные формы –
внутриклеточные формы,
способны к размножению.
Покоящиеся формы – сохранение
во внешней среде, проникновение
в клетку.
5. Тинкториальные свойства
6. Культуральные свойства
Риккетсии – облигатные
паразиты → культивируются:
в желточном мешке куриных
эмбрионов,
на перевиваемых культурах
клеток,
на чувствительных животных
(мыши, морские свинки,
кролики).
7. Патогенность
Факторы адгезии (мембранные белки
Оmp А, Оmp B);
гемолизины;
факторы инвазии – фосфолипаза А;
термолабильный белковый токсин,
прочно связанный с телом клетки,
вызывает гибель мышей от острой
интоксикации через 4 – 24 ч;
ЛПС – эндотоксин.
8. Антигенные свойства
1. Поверхностный термостабильный,
растворимый (липидо-полисахаридобелковый комплекс) общий у
возбудителей эпидемического и
эндемического сыпного тифа и с АГ
протея – Х2, Х19;
2. Внутренний термолабильный,
видоспецифический – полисахаридобелковый комплекс.
9. Общая характеристика риккетсий
Переносчики –
членистоногие (вши,
блохи).
Риккетсиемия,
генерализация
инфекции.
Эндотелиоз, лихорадка.
Серодиагностика.
Антибиотикотерапия.
11. Возбудитель эпидемического сыпного тифа
Rickettsia prowažekii.
Лихорадка, интоксикация,
специфическая розеолезнопетехиальная сыпь, поражение
сосудистой и ЦНС.
Эпидемии – чаще во время войн,
голода и других социальных
потрясений → снижение
санитарно-гигиенического уровня
→ распространение педикулеза.
Летальность в
«доантибиотическую» эру – до
80%.
12. Патогенез
13. Патогенез
Риккетсии → кровь → клетки эндотелия кровеносных
сосудов, размножаются → эндотоксин.
Эндотелиальные клетки разрушаются → риккетсии
поступают в кровь.
Ретикулоэндотелиоз → нарушение микроциркуляции
в головном мозге, миокарде, почках → сыпь,
менингоэнцефалит, миокардит, гломерулонефрит.
Сыпь: расширение капилляров кожи (розеолезная
сыпь) и их повреждения с кровоизлиянием
(петехиальная сыпь). Локализация – грудь, живот,
спина, конечности за исключением лица, ладоней,
подошв.
Человек – биологический тупик.
Персистенция на территории костного мозга в виде Lформ и → рецидив сыпного тифа – болезнь Брилла.
14. Сравнительная характеристика сыпного тифа и болезни Брилла
Диф. признаки
Анамнез по
сыпному тифу
Контакт с больным
(через вшей)
Возраст
Иммуноглобулины
Сыпной тиф
Болезнь Брилла
_
+
+
_
любой
взрослые и
пожилые
Сначала IgM,
затем IgG
IgG
15. Саногенез
Стойкий, длительный иммунитет –
антибактериальный и антитоксический.
Болезнь Брилла – возможность
активизации в организме риккетсий в
результате снижения иммунитета.
16. Микробиологическая диагностика
1. + . РИФ.
2. – . Возможен в специальных лабораториях.
3. – . Дифференциальная диагностика с
эндемическим сыпным тифом: «скротальный
феномен».
4. + . РНГА, РА, РСК, НРИФ.
5. – .
17. Лечение и профилактика
Вакцина Е сыпнотифозная комбинированная
живая сухая (ЖКСВ-Е) – риккетсии Провачека
авирулентного штамма Мадрид Е,
выращенные в желточных мешках куриных
эмбрионов + растворимый АГ вирулентного
штамма Брейль.
Вакцина сыпнотифозная химическая сухая.
Неспецифическая профилактика –
ликвидация педикулеза, его профилактика,
ранняя диагностика и полноценное лечение
больных сыпным тифом.
18. Другие риккетсиозы
Rickettsia typhi (R.mooseri) –
возбудитель эндемического
(блошиного или крысиного)
сыпного тифа.
Rickettsia rickettsii – возбудитель
лихорадки скалистых гор.
Rickettsia conori – возбудитель
марсельской лихорадки (клещевой
средиземноморской лихорадки).
Rickettsia sibirica – возбудитель
клещевого сыпного тифа
(клещевой риккетсиоз
североазиатский).
20. Возбудитель Ку-лихорадки
от англ. Query – непонятно;
зоонозная инфекция, вызываемая
Coxiella burnetii, характеризуется
полиморфной клинической картиной с
преимущественным поражением
легких.
Коксиеллы могут долго сохраняться в
пыли, в продуктах.
21. Таксономическое положение
22. Патогенез
23. Микробиологическая диагностика
1. – .
2. – .
3. + Возбудитель можно выделить из крови,
мокроты, мочи. С этой целью морским
свинкам, мышам вводят материал от
больного. Из селезенки зараженного
животного возбудителей выделяют путем
культивирования на курином эмбрионе.
4. + РА, РСК, ИФА.
5. + Кожно-аллергическая проба с Ку-АГ.
24. Лечение и профилактика
Лечение – антибиотики
тетрациклиновой группы.
Профилактика – живая вакцина из
штамма М-44.
Неспецифическая профилактика –
санитарно-ветеринарные мероприятия
и соблюдение личной гигиены.
25. Эрлихии
26. Таксономическое положение
Family:
Ehrlichiaceae
Genus: Ehrlichia
Species: E. chaffeensis
Genus: Anaplasma
Species: A. phagocytophilum
27. Эрлихии
Эрлихиозы – остролихорадочные,
инфекционные болезни человека и животных.
Возбудители – грамотрицательные,
риккетсиоподобные, облигатные
внутриклеточные микроорганизмы.
Наибольшее медицинское значение:
• E. chaffeensis – моноцитарный эрлихиоз;
• A. phagocytophilum (E. phagocytophila) –
гранулоцитарный эрлихиоз.
28. Эрлихиозы
Переносчики: Ixodes ricinus;
Ixodes scapularis; Dermacentor
variabilis.
Механизм передачи:
трансмиссивный.
Первичный аффект
→Лимфаденит→кровь→гранулемы
Материал для исследования –
кровь больного в острой фазе
заболевания.
Методы: бактериоскопический;
серологический (ИФА); ПЦР.
29. Хламидии
30. Таксономическое положение
Family: Chlamydiaceae
Genus: Chlamydia
Species:
C.trachomatis
Genus:Chlamydophila
Species:
C.pneumoniae;
C.psittaci
31. Морфология
Мелкие неподвижные
бескапсульные
грамотрицательные
облигатно паразитические
бактерии (энергетические
паразиты).
Формы: элементарные,
ретикулярные тельца,
промежуточные формы.
Внутриклеточные формы
(микроколонии) –
хламидийные включения.
тельца
Гальберштедтера-Провачека
32. Цикл развития хламидий
33. Общие свойства хламидий
Методы выявления:
• Романовского-Гимза,
• люминисцентная
микроскопия,
• электронная микроскопия.
Культивирование: на
куриных эмбрионах, в
организме лабораторных
животных, в культуре
клеток.
Патогенность: эндотоксин.
34. Антигены хламидий
Родоспецифический
(общий) – липосахарид.
Видоспецифический
(различен для C.psittaci,
C.trachomatis,
C.pneumoniae) – белок.
Типоспецифический
(различен для сероваров • А, В, Ва и С – «глазные»
Chlamydia trachomatis ) –
серовары (трахома);
белок. Выделяют 15
• D – К – «генитальные»
сероваров (от А до L).
серовары
(урогенитальный хламидиоз);
• L и Ly – ВЛГ.
35. Chlamydia trachomatis
Трахома (хронический
кератоконъюнктивит), острый
конъюнктивит (А, В, Ва и С );
вульвовагинит, уретрит,
цервицит, сальпингит (D – К );
ринофарингит, бронхит,
пневмония, отит, синусит;
паховая (венерическая)
лимфогранулема (L и Ly);
миокардит, менингоэнцефалит;
синдром Рейтера.
36. Хламидиоз у детей
Chlamydia trachomatis.
Интранатальное
инфицирование
новорожденных.
Антенатальное
(внутриутробное)
инфицирование → хламидиоз
новорожденных:
• гастроэнтеропатия;
• внутриутробный сепсис;
• синдром дыхательных
• менингоэнцефалит;
расстройств;
• внутриутробная пневмония; • конъюктивит;
• вульвовагинит.
37. Chlamydophila pneumoniae
Тропизм к эпителию респираторных
путей.
Источник - больной,
Респираторный хламидиоз:
фарингиты, лимфаденопатии,
бронхиты, пневмонии.
Часть случаев протекает
субклинически (АТ к C.pneumoniae
выявляют почти у 50% взрослого
населения), однако диагностируются
до настоящего времени плохо.
Развитие отдельных форм
бронхиальной астмы и
атеросклероза.
38. Chlamydophila psittaci
Орнитоз, генерализованный
хламидиоз.
Источник инфекции: птицы
(голуби, канарейки, попугаи).
Пути заражения: воздушно –
пылевой, алиментарный.
Наиболее поражаемые органы:
легкие, печень, селезенка,
почки, сердце.
39. Микробиологическая диагностика хламидиозов
Материал: соскоб из уретры или цервикального канала,
соскоб с конъюнктивы глаз, секрет предстательной
железы, осадок мочи, сыворотка крови.
Микроскопический: цитологическое исследование
мазков, окрашенных по Романовского-Гимза – телеца
Гальбершедтера-Провачека (острые инфекции). РИФ.
Бактериологический (культуральный):
культивирование на клетках Hela или McCoy,
идентификация, чувствительность к антибиотикам,
продолжительность исследования – 4-7 дней. ИФА.
ПЦР.
Биологический: «–».
Серологический: РСК, НРИФ, ИФА.
Аллергологический: Внутрикожная проба с орнитином.
40. Патогенные грибки
41. Таксономическое положение
Царство—Грибки (Mycota или Fungi)
Отдел Eumycota
Классы:
Zygomycetes (включают род Mucor, способен
вызывать мукоромикоз человека и животных).
Ascomycetes (или сумчатые грибки, относятся
к высшим грибкам, к ним относятся роды
Aspergillus, Penicillium, а также дрожжевые
грибки).
Deuteromycetes – несовершенные грибки, не
размножаются половым путем (Candida).
Histoplasma, Cryptococcus, Blastomyces и др
42. Blastomycetes
Дрожжи – изолированные
округлые клетки →
одноклеточные
организмами.
Колонии похожи на
бактериальные –
гладкие, пастообразные,
вырастают через 24-48 ч.
43. Hyphomycetes
Плесени образуют
мицелий, который
состоит из гиф →
многоклеточные
организмы.
Колонии пушистые, часто
пигментированные,
созревающие медленнее.
Споры, говорящие о
зрелости плесневых
колоний, появляются на 47 сут.
44. Микозы
Поверхностные микозы –
разноцветный (отрубевидный)
лишай, себорейный дерматит.
Дерматомикозы
(дерматофитии) – поражается
кожа и ее придатки (волосы и
ногти). Микроспория,
трихофития и эпидермофития.
Глубокие микозы (системные)
– гистоплазмоз, бластомикоз,
кокцидиомикоз.
45. Особенности диагностики микозов
Микоскопический метод: неокрашенные (нативные)
и окрашенные препараты (по Граму, РомановскомуГимзе, Цилю-Нильсену и др. РИФ. Гистологическое
исследование – грибок в тканях.
Микологический метод: выделение чистой культуры
грибка и ее идентификация. Среды Сабуро, суслоагар, Чапека, кукурузный, рисовый, картофельный
агар и др. Определение чувствительности грибков к
противогибковым препаратам. Выявление грибковых
АГ, специфических метаболитов и генетических
маркеров (ПЦР).
Биологический метод. Редко.
Серологический метод: РА, РП, РНГА, ИФА, РИФ,
иммуноблоттинг.
Аллергологический метод: «+».
46. Candida
C. аlbicans;
реже – C.glabrata,
C.tropicalis,
C.lusitaniae,
C.parapsilosis,
C.krusei.
1 – нити псевдомицелия;
2 – дрожжевые клетки –
бластоспоры;
3 – хламидиоспоры.
47. Кандидоз
C.albicans – комменсал.
Кандидоз –
оппортунистический микоз
Инфицирование –
эндогенное, экзогенное
(особенно в госпитальных
условиях).
Кандидоз: поражение кожи
и слизистых оболочек
(молочница); системное
поражение (пневмония,
менингит, эндокардит,
остеомиелит, артрит и др.).
48. Микробиологическая диагностика
1. Микоскопический – «+».
2. Микологический – «+»,
ПЦР.
3. Биологический – «–».
4. Серологический – РА, РП,
РСК, РНГА, ИФА.
5. Аллергологический – «+».
Орнитоз
Орнитоз – хламидийная инфекция, протекающая с преимущественным поражением дыхательной системы. Клинические проявления орнитоза включают лихорадочно-интоксикационный синдром, пневмонию, конъюнктивит, гепатолиенальный синдром, признаки нейротоксикоза и менингизма. Диагноз орнитоза подтверждается данными серологических исследований (РСК, РТГА, РИФ, ИФА), микроскопии мокроты, рентгенографии легких. Этиотропная терапия орнитоза проводится антибактериальными препаратами из группы макролидов, фторхинолонов и тетрациклинов; дополнительно используются бронхолитики, противокашлевые препараты, витамины.
Общие сведения
Орнитоз (респираторный хламидиоз, пситтакоз, болезнь попугаев) – зоонозная инфекция, специфическими возбудителями которой выступают хламидии, а источником – птицы. Орнитоз является повсеместно распространенным заболеванием, что обусловлено миграцией птиц. В структуре острых пневмоний, регистрируемых в различных регионах мира, 10-20% случаев имеют орнитозную этиологию. Этот факт требует повышения уровня эпидемической настороженности в отношении орнитоза со стороны специалистов в области пульмонологии. В большинстве случаев регистрируются спорадические случаи орнитоза; реже – семейные, групповые и производственные вспышки. Среди заболевших орнитозом преобладают пациенты среднего и старшего возраста; у детей инфекция развивается сравнительно нечасто.
Причины орнитоза
Заболевание вызывается облигатным внутриклеточным паразитом Chlamydophila psittaci. Особенности жизнедеятельности хламидий обусловливают специфику течения орнитоза. К таким особым свойствам относятся способность возбудителя к размножению внутри клеток, образованию L-формы и сохранению вирулентности в различных условиях, выделению экзо- и эндотоксина, тропизм к клеткам респираторного тракта и системы мононуклеарных фагоцитов и т. д. Возбудитель орнитоза проявляет относительную устойчивость во внешней среде, хорошо переносит низкие температуры. Вместе с тем, быстрая инактивация хламидий наступает при нагревании, воздействии хлорсодержащих дезинфицирующих средств, ультрафиолета, антисептиков.
Природным источником и резервуаром орнитозной инфекции выступают дикие и домашние, в т. ч. декоративные птицы, которые являются бактерионосителями или переносят заболевание в форме ринита или острой кишечной инфекции. Носителями Chlamydophila psittaci могут являться свыше 150 видов птиц, чаще - попугаи, канарейки, утки, куры, индюшки, вороны, голуби (в городах зараженность голубей орнитозом достигает 50-80%). Птицы могут передавать возбудителя потомству на протяжении 2-х и более поколений. В окружающую среду возбудитель орнитоза попадает вместе с носовым секретом и фекалиями птиц. Заражение человека может происходить различными путями: аэрогенным (при вдыхании возбудителя с пылью), контактно-бытовым (через загрязненные возбудителем перья, яйца, предметы обихода) и фекально-оральным (при употреблении инфицированной пищи или занесении возбудителя в рот с грязных рук). В группу повышенного риска по заболеваемости орнитозом входят работники птицеферм, и птицефабрик, зоомагазинов, заводчики голубей и декоративных птиц, а также сельские жители, содержащие на своем подворье домашнюю птицу.
Основной мишенью возбудителя орнитоза в организме человека служат клетки цилиндрического эпителия дыхательных путей, лимфоидные и ретикулогистиоцитарные клетки, в которых происходит размножение и накопление хламидий. Через 2-3 суток пораженные клетки разрушаются, а хламидии, их токсины и продукты жизнедеятельности попадают в кровь, вызывая симптомы аллергизации и интоксикации. Гематогенное распространение возбудителей по организму приводит к поражению легких, миокарда, головного мозга, печени. Патоморфологические изменения во внутренних органах при орнитозе включают очагово-сливную бронхопневмонию, увеличение перибронхиальных и бифуркационных лимфоузлов, гепато- и спленомегалию, дистрофические изменения в паренхиматозных органах. Поскольку хламидии склонны к длительной внутриклеточной персистенции, орнитоз нередко принимает затяжное рецидивирующее течение с образованием ателектазов легких и развитием очагового фиброза или диффузного пневмосклероза.
Симптомы орнитоза
Клиническое течение орнитоза проходит инкубационный период (1-3 недели), продромальный период, период клинических проявлений и период выздоровления. Заболевание может протекать в респираторной, гриппоподобной, тифоподобной, менингеальной и генерализованной форме, а также в остром или хроническом варианте.
Перед манифестацией специфических симптомов острого орнитоза в течение 3-5 дней отмечаются продромальные явления, характеризующиеся недомоганием, общей слабостью, тошнотой, потерей аппетита, субфебрилитетом. Вслед за этим развивается лихорадка с температурой до 39-40°С, которая через несколько суток снижается литически. В лихорадочный период выражены жажда, сухость во рту, миалгии и артралгии. Отмечаются слабо выраженные катаральные явления: першение и боль в горле, насморк, гиперемия слизистой глотки, ларингит. Вследствие тропности возбудителя орнитоза к эндотелию сосудов возникает конъюнктивит, инъекция сосудов склер, носовые кровотечения, кожная сыпь пятнисто-папулезного или розеолезного характера.
На 3-5 сутки к общеинфекционным симптомам присоединяются признаки поражения легких: боли в грудной клетке, сухой, а затем продуктивный кашель со слизисто-гнойной мокротой. Рентгенологически определяются признаки интерстициальной, мелко- или крупноочаговой, долевой орнитозной пневмонии. К исходу первой недели заболевания увеличивается печень. Для орнитоза характерно поражение нервной системы с признаками нейротоксикоза: головной болью, адинамией, бессонницей, депрессией, при тяжелом течении – галлюцинациями, бредом, эйфорией. Возможно развитие серозного менингита с доброкачественным течением.
Гриппоподобная форма орнитоза характеризуется, главным образом, симптомами общей интоксикации. Тифоподобный вариант инфекции протекает с лихорадкой ремитирующего типа, гепатоспленомегалией и нейротоксическими проявлениями. При менингеальной форме орнитоза на первый план выходят симптомы менингизма. При любой из клинических форм орнитоза реконвалесценция растягивается на 2-3 месяца; в этот период сохраняется астенизация, быстрая утомляемость, снижение трудоспособности, артериальная гипотония, признаки вегето-сосудистой дистонии (акроцианоз, ладонный гипергидроз, тремор, зябкость конечностей). У 10-12% пациентов орнитоз принимает хроническое течение, чаще в виде хронического бронхита или пневмонии с длительным субфебрилитетом, увеличением печени и селезенки, астеновегетативным синдромом.
К редким осложнениям орнитоза относятся: гепатит, нефрит, миокардит, полиневрит, иридоциклит, тиреоидит и др. У беременных орнитоз может вызывать самопроизвольное прерывание беременности.
Диагностика и лечение орнитоза
Основу для постановки клинического диагноза представляют данные эпиданамнеза (тесное контактирование с птицами, групповая заболеваемость) и характерная симптоматика (лихорадка, пневмония, гепатолиенальный синдром и др.). Для лабораторного подтверждения орнитоза проводится микроскопическое исследование мокроты, серологическая диагностика (РИФ, РСК, РТГА, ИФА), исследование биоптатов бронхов, полученных в ходе бронхоскопии, биопроба на куриных эмбрионах.
Орнитозная пневмония диагностируется с помощью физикального обследования и рентгенографии легких. При менингеальных симптомах проводится спинномозговая пункция с исследованием цереброспинальной жидкости. Возможно проведение и анализ внутрикожной аллергической пробы с инактивированной культурой возбудителя орнитоза. Дифференциальная диагностика направлена на исключение ОРВИ, гриппа, атипичной пневмонии, инфекционного мононуклеоза, бруцеллеза, лихорадки Ку, туберкулеза, легионеллеза, глубоких микозов (аспергиллеза, гистоплазмоза, нокардиоза, кокцидиоидоза).
Комплексное лечение орнитоза складывается из этиотропной, патогенетической и симптоматической терапии. Базовыми препаратами для специфической терапии орнитоза служат антибиотики тетрациклинового ряда, макролиды, фторхинолоны, обладающие антихламидийной активностью. При острой форме орнитоза длительность антибактериального курса составляет 10-14 дней; при хроническом течении проводится 2-3 курса антибиотикотерапии с интервалом 7-10 дней и сменой препарата. Патогенетическая терапия орнитоза включает назначение иммуномодуляторов, иммуностимуляторов, поливитаминов, проведение дезинтоксикационных мероприятий. Симптоматическую направленность носит прием жаропонижающих, противокашлевых средств, муколитиков.
Прогноз и профилактика орнитоза
Исход орнитоза, как правило, благоприятный. Однако примерно у четверти больных в ранние (2-4 недели) или поздние сроки (4-6 месяцев) развиваются рецидивы заболевания. При своевременном лечении осложнения орнитоза возникают редко. К числу наиболее опасных из них, сопряженных с риском летального исхода, относятся острая сердечная недостаточность, ТЭЛА. Иммунитет после перенесенного орнитоза нестойкий, возможны повторные случаи заражения.
Неспецифические профилактические мероприятия предусматривают ограничение контакта с птицами, усиление ветеринарного контроля за содержанием птиц на птицефермах и в зоопарках, уничтожение инфицированного поголовья. В очагах орнитоза проводится дезинфекция; лица, подвергшиеся контакту с больными птицами, подлежат медицинскому наблюдению в течение 30 дней с проведением химиопрофилактики инфекции.
Читайте также:
